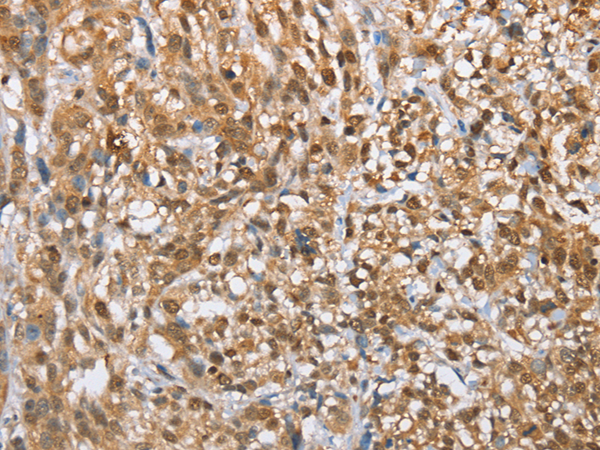

中文名稱: 兔抗MMP12多克隆抗體
英文名稱: Anti-MMP12 rabbit polyclonal antibody
別 名: ME; HME; MME; MMP-12
抗 原: MMP12
儲(chǔ) 存: 冷凍(-20℃)
宿 主: Rabbit
相關(guān)類別: 一抗
反應(yīng)種屬: Human
標(biāo) 記 物: Unconjugate
克隆類型: rabbit polyclonal
技術(shù)規(guī)格
|
Background: |
Proteins of the matrix metalloproteinase (MMP) family are involved in the breakdown of extracellular matrix in normal physiological processes, such as embryonic development, reproduction, and tissue remodeling, as well as in disease processes, such as arthritis and metastasis. Most MMP's are secreted as inactive proproteins which are activated when cleaved by extracellular proteinases. It is thought that the protein encoded by this gene is cleaved at both ends to yield the active enzyme, but this processing has not been fully described. The enzyme degrades soluble and insoluble elastin. |
|
Applications: |
ELISA, WB, IHC |
|
Name of antibody: |
MMP12 |
|
Immunogen: |
Fusion protein of human MMP12 |
|
Full name: |
matrix metallopeptidase 12 (macrophage elastase) |
|
Synonyms: |
ME; HME; MME; MMP-12 |
|
SwissProt: |
P39900 |
|
ELISA Recommended dilution: |
5000-10000 |
|
IHC positive control: |
Human thyroid cancer and human esophagus cancer |
|
IHC Recommend dilution: |
50-200 |
|
WB Predicted band size: |
54 kDa |
|
WB Positive control: |
293T cell lysate |
|
WB Recommended dilution: |
200-1000 |

購物車
幫助
021-54845833/15800441009
